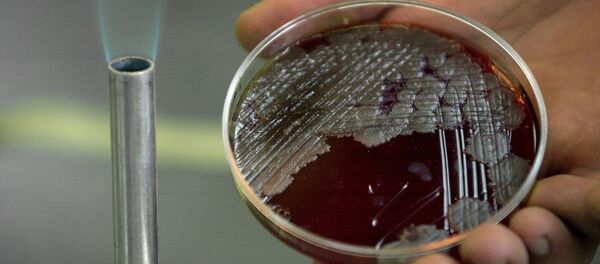
炭疽菌のサンプル 炭疽菌のサンプル - Sputnik 日本

プーチン大統領は類似した課題を近い将来における東シベリアおよび極東発展のために定めており、パク大統領のイニシアチブに支持を示している。新生ロシアの歴史で自由港のような、こうした社会経済発展メカニズムがスタートするのは初めてのことだ。同時に世界の経験からこのメカニズムが効果が高いことは示されている。
パク・ロビョク駐露韓国大使はユーラシア・イニシアチブに対する自らの見解を次のように語っている。
これはプーチン大統領の構想にそうだけではなく、この地域のあらゆる国の利益に叶う。このことからパク・ロビョク駐露韓国大使は、今日、二国間関係で最も主要な最優先方向性は経済協力の活性化であるとの見方を示し、さらに次のように語っている。
「ウクライナ危機は国際舞台の変化、ルーブル・レートの下落、一連の問題を引き起こし、これによってロシア市場は景気後退の時期に突入し、韓国企業も困難に直面してしまった。このため、ロシア市場が復活するように、政府は再び支援策を行なわねばならないと思う。
そうした最優先の方向性の中で私が注目するのは次のものだ。
ひとつはロシアが必要な産業の多極化が図れるために、極東に特別経済区および先進発展区域の創設を完了させねばならない。そしてこれらのゾーンで地域のロジスティックス、農業、健康保険、医薬品など中小企業を引き入れながら集中して協力を発展させていく。これは韓国企業にとってロシアとの協力プロジェクトを実現化させるための好条件を作るだろう。
このほか、ロシアと韓国の協力は北朝鮮側からの軍事的煽動の数を減らすため、特に安全保障分野での安定化のために重要だ。特に、鉄道およびインフラ分野のパイロット・プロジェクトの将来性はこれにかかっていると思う。」
ユーラシア・イニシアチブは現時点では実現の初期段階にあるが、重要なのはロシア政府がそれを支持していることだ。それとおそらく、パク大使はこれをソフトなテーマから始めていることは正しいとの考えを示している。たとえば、エネルギー安全保障、原子力エネルギーの安全保障といったテーマだ。パク大使は、こうしたことは将来、地域全体の安全という重要課題を保障することになるメカニズムの創設を除外するものではないとの見方を示している。